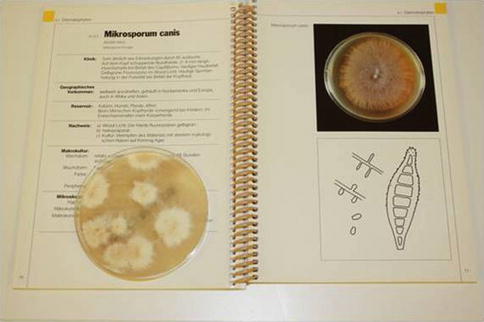
A325970_1_En_2_Fig4_HTML.jpg

(1)
Dermatologische Praxis & Haarcenter, Wallisellen (Zürich), Switzerland
Try not to become a man of success, but rather try to become a man of value.
Albert Einstein (1879–1955)
As with any medical problem, the patient complaining of hair loss requires a comprehensive medical and drug history, physical examination of the hair and scalp, and appropriate laboratory evaluation to identify the cause. The clinician also has a host of diagnostic techniques that enable classification of the patient’s disorder as a shedding disorder or a decreased density disease and documentation of true pathology or only perceived pathology.
Prerequisite for delivering appropriate patient care is an understanding of the underlying pathologic dynamics of hair loss and a potential multitude of cause relationships. By approaching the hair loss patient in a methodical way, commencing with the simplest and easiest to recognize objects, and ascending step by step to the knowledge of the more complex, an individualized treatment plan can be designed.
It must be borne in mind that hair loss often does not result from a single cause effect, but from a combination of factors that all need to be addressed simultaneously for success. Therefore, it is wise to divide each of the difficulties under examination into as many parts as possible, and as might be necessary for its adequate solution, and finally to make enumerations so complete and reviews so general, so that nothing is omitted that might compromise success. For this purpose it is advisable to design a hair database sheet that enables a complete record of collected data.


2.1 Patient History
History taking is of paramount importance in assessing hair loss. By careful and systematic questioning, it is possible to assess the factors pertinent to differential diagnosis and particular lines of further investigation.
In the course of history taking, it is advisable never to accept anything for true, neither from the patient nor from the referring physician, which is not clearly recognizable as such, that is to say, carefully to avoid precipitancy and prejudice and to comprise nothing more in one’s judgment than what is presented to the mind so clearly and distinctly as to exclude all grounds of doubt.
A detailed family history relating to hair loss is pertinent to the diagnosis of genetic disorders.
While monogenic disorders are usually determined by one gene that has a strong influence on the phenotype, polygenic traits are likely to be determined by a large number of genes that confer variable levels of risk. Moreover, complex polygenic traits usually are not binary in nature, that is, the trait does not exist as one state or the other, such as affected or not affected. More so, the trait presents as a continuous variable that shows a normal distribution across a population. Ultimately, genetic sequence variation is not the only contributing factor that determines the trait. Environmental influences also play a role. It is this synergistic interplay between genes and environment that determines a complex phenotype.
In everyday clinical practice, we are usually dealing with androgenetic alopecia that represents a complex polygenic trait. The genetic involvement is pronounced, and the importance of genes concurs with marked sex-dependent and racial differences in prevalence of androgenetic alopecia. The high frequency of androgenetic alopecia has complicated attempts to establish a mode of inheritance.
As a rule, the risk of premature hair loss usually rises with the frequency and extent of the balding trait within first-degree relatives, while a negative family history does not exclude the diagnosis in a particular individual.
The personal history encompasses on:
Date of onset of the hair loss problem
Periodicity of hair loss
Rate of progression
Previous investigations and treatments
Present and past medical history
Medications, including hormone active treatments (anabolics, oral contraceptives, hormone replacement therapy)
Associated symptoms relating to the general health status
Associated symptoms relating to the condition of the scalp
Associated symptoms relating to the condition of the scalp may be:
Greasiness (seborrhea)
Dryness (sebostasis)
Itchiness (pruritus)
Dandruff
Burning sensations or hair pain (trichodynia)
Scratching habit (15 min of scratching will lead to breakage of hair)
Women often blame hair cosmetics for their hair loss, while some men suspect wearing hats or helmets as the culprit.
The fact is that neither washing nor blow drying affects the condition of the hair follicle and therefore has no impact on hair growth. Nevertheless, overaggressive shampooing, toweling, and excessive heat from blow dryers may cause physical damage to the hair shaft resulting in brittle hair.
Unless a headdress is worn tight enough to cause long-standing pressure to the scalp or traction to the hair, wearing a hat does not cause hair to fall. The perception of hair loss in association with the wearing of hats or helmets derives from the fact that male pattern baldness typically starts at an age in which young men become active in the military or in professions with headgears. It represents nothing more than a temporal coincidence.
Frequently, patients claim of hair loss in association with the use of a particular shampoo, typically an anti-dandruff shampoo. This observation is easily explained either through the more intense scrubbing of the head with a special care shampoo causing more telogen hairs to be shed, or the shedding of telogen hairs trapped in scales, once these are effectively removed from the scalp.
Diffuse hair loss due to an inhibition of mitosis associated with long-term use of shampoos containing keratostatic anti-dandruff agents, such as selenium sulfide, has been discussed in the older literature, but remains controversial. However, absence of effects of dimethicone- and non-dimethicone-containing shampoos on hair loss rates has systematically been demonstrated.
With respect to hairstyling, it is rather the particular hairstyle than the styling product, such as gels, pomades, hair sprays, perm solutions, or coloring, that may result in hair loss. Anything causing long-standing traction to the hair, such as tight ponytails, cornrows, or chignons, will lead to focal hair loss, particularly in association with androgenetic alopecia. Ultimately, the use of chemicals and heat as well as braiding is relevant to central centrifugal cicatricial alopecia in black women.
Finally, acute telogen effluvium may be induced by allergic contact dermatitis to hair dyes, particularly to paraphenylenediamine. In these cases, patch testing will reveal the culprit.
For a proper appreciation of the condition of the hair shaft and hair breakage as it relates to hair care and grooming habits, inquiries should be made on:
Frequency and type of shampooing
Use of hair care products
Hairstyling products
Hair coloring agents
Hair curling or hair straightening
Hair grooming habits
The medical history should focus on most frequent causes of hair loss:
Drug-induced hair loss is usually a diffuse non-scarring alopecia that is reversible upon withdrawal of the drug. Only a few drugs, mainly antimitotic agents, regularly cause hair loss, whereas many drugs may be the cause of isolated cases of alopecia. There is a long list of drugs that on occasion have been cited as causing hair loss: all anticoagulant and antithyroid drugs can produce hair loss; some psychotropic drugs are likely to induce a drug-related alopecia; it has been reported that some patients taking lithium developed hair thinning; case reports with tricyclic antidepressants rarely appear in the literature; hair loss is reported secondary to some anticonvulsant agents, mainly valproic acid; among antihypertensive drugs, ACE inhibitors and systemic or topic beta-adrenoceptor antagonists (for treatment of glaucoma) should be considered as possible causes of hair loss; hair loss from nonsteroidal analgesics occurs in a very small percentage of patients; and a few isolated cases have been reported with some hypocholesterolemic or anti-infectious agents.
Regularly, contraceptive pills or hormone replacement therapies with progestogens that possess net androgenic activity, such as norethisterone, levonorgestrel, and tibolone, induce hair loss in genetically predisposed women. It has been proposed that in the presence of a genetic susceptibility, it is the estrogen to androgen ratio that might be responsible for triggering hair loss in women. In the same line is the observation of hair loss induced in the susceptible women by treatment with aromatase inhibitors for breast cancer.
Diagnosis of drug-induced alopecia remains a challenge. The clinical identification of adverse drug reactions has been based largely on subjective criteria.
However, the possible culprit of an adverse drug reaction can systematically be assessed based on the following six variables: previous experience with the drug in the general population, alternative etiological causes (usually androgenetic alopecia or may be caused by the disease that is treated with the drug in question), timing of events, drug levels or evidence of overdose, patient reaction to removal of the suspected drug, and patient reaction to rechallenge.
Finally, a history should be taken of:
Dietary behavior and alcohol abuse
UV exposure
Cigarette smoking
Sexual risk behavior and drug abuse (syphilis, HIV infection)
Stressful life events
The quantity and quality of hair are closely related the nutritional state of an individual. Normal supply, uptake, and transport of proteins, calories, trace elements, and vitamins are of fundamental importance in tissues with a high biosynthetic activity such as the hair follicle. Because hair shaft is composed almost entirely of protein, protein component of diet is critical for production of normal healthy hair. The rate of mitosis is sensitive to the calorific value of diet, provided mainly by carbohydrates stored as glycogen in the outer hair root sheath of the follicle. Finally, a sufficient supply of vitamins and trace metals is essential for the biosynthetic and energetic metabolism of the follicle.
In instances of protein and calorie malnutrition, deficiency of essential amino acids, of trace elements, and of vitamins, hair growth and pigmentation may be impaired. In general, malnutrition is due to one or more of following factors: inadequate food intake, food choices that lead to dietary deficiencies, and illness that causes increased nutrient requirements, increased nutrient loss, poor nutrient absorption, or a combination of these factors.
It appears that on a typical Western diet, the hair follicle should have no problem in producing an appropriate hair shaft.
Nevertheless, vitamin and nutritional deficiencies are not uncommonly observed in adolescents feeding on “junk food,” people on fad diets, alcoholics, and the chronically ill, and especially common in the elderly population.
As the rest of the skin, the scalp and hair are exposed to noxious environmental factors. While UV radiation (UVR) and cigarette smoking are well appreciated as major factors contributing to extrinsic aging of the skin, their effect on the condition of hair and the natural course of androgenetic alopecia have only later attracted the attention of the medical community.
While the consequences of sustained UVR on unprotected skin are well appreciated, mainly photocarcinogenesis and solar elastosis, the effects of UVR on the evolution of androgenetic alopecia have largely been ignored. However, some clinical and morphological observations, as well as theoretical considerations, suggest that UVR has some negative effect:
Camacho et al. reported a peculiar type of telogen effluvium following sunburn of the scalp after 3 to 4 months with hairstyles that left areas of scalp uncovered during prolonged sun exposure. The clinical features were increased frontovertical hair shedding along with a trichogram that disclosed an increase of telogen hairs and dystrophic hairs. In women the hairs on the frontal region appeared unruly and the frontovertical alopecia showed loss of the frontal hair implantation line.
Ultimately, elastosis is regularly found histopathologically in scalp biopsies, especially in alopecic conditions, but so far has largely been ignored. Up to date, no controlled study has been performed on the degree of scalp elastosis in relation to the pace of development, duration, or grade of androgenetic alopecia, though it would seem to be a good marker for exposure to UVR penetrating the skin.
In 1996, Mosley and Gibbs originally reported a significant relationship between smoking and premature gray hair in both men and women and between smoking and baldness in men. Since the number of alopecia in women was very small, no corresponding calculation could be carried out for hair loss in women.
Eventually, a population-based cross-sectional survey among Asian men 40 years or older showed statistically significant positive associations between moderate or severe androgenetic alopecia and smoking status, current cigarette smoking of 20 cigarettes or more per day, and smoking intensity. The odds ratio of early-onset history for androgenetic alopecia grades increased in a dose–response pattern. Risk for moderate or severe androgenetic increased for family history of first-degree and second-degree relatives, as well as for paternal relatives.
The well-recognized psychological effects of alopecia and our society’s veneration of youth and its attributes seem to offer a good opportunity for prevention or cessation of smoking by increasing public awareness of the association between smoking and hair loss.
Finally, a history of sexual risk behavior and drug abuse may be relevant with respect to hair loss due to syphilis or HIV infection.
After decreasing drastically with the availability of penicillin for treatment in the 1940s, rates of syphilis infection have increased since the turn of the millennium, often in combination with human immunodeficiency virus. This has been attributed partly to unsafe sexual practices among men who have sex with men, increased promiscuity, prostitution, and decreasing use of condoms.
The literature on the subject of hair loss due to stressful life events has been more confounding than helpful. The presence of emotional stress is not indisputable proof of its having incited the patient’s hair loss. The relationship may also be the inverse. Nevertheless, it has long been recognized that psychosomatic factors play a role in dermatologic conditions. According to the psychosomatic theory, an organ system is vulnerable to psychosomatic ailments when several etiologic factors are operable. These include:
Emotional factors mediated by the central nervous system
Intrapsychic processes such as self-concept, identity, or eroticism
Specific correlations between the emotional drive and the target organ, i.e., social values and standards linked with the organ system
Constitutional vulnerability of the target organ
Ultimately, the issue of overvalued ideas in relation to the condition of the hair is not always easy to resolve; however, it is important to control stress as a complication of hair loss or fear of hair loss. For this purpose, strong psychological support is essential to help limit patient anxiety, and patients need to be educated about the basics of the hair cycle. Information about the hair cycle can be useful to explain why considerable patience is required for effective cosmetic recovery.
The best way to alleviate the emotional distress caused by hair disease is to eliminate the hair disease that is causing the problem. For a successful encounter at an office visit, one needs to be sure that the patient’s key concerns have been directly and specifically solicited and addressed.
2.2 Examination Techniques
The skin and hair are gratifying for diagnosis. One has but to look and recognize, since everything to be named is in full view. Looking would seem to be the simplest of diagnostic skills, and yet its simplicity lures one into neglect. To reach the level of artistry, looking must be a skilful active undertaking. The skill comes in making sense out of what is seen, and it comes in the quest for the underlying cause, once the disorder has been named. The first look is best made without prejudices of former diagnoses and without bias of laboratory data. In many instances a specific diagnosis is made in a fraction of a second if it is a simple matter of recognition. The informed look is the one most practiced by dermatologists; it comes from knowledge, experience, and visual memory.
Where the diagnosis doesn’t come from a glance, the diagnostic tests come in, i.e., the dermatological techniques of examination and the laboratory evaluation. Access to the following diagnostic tools and facilities may be required for diagnosis:
Clinical examination (scalp, complete skin, nails, mucous membranes, pattern recognition)
Dermatological techniques (black and white felt examination, assessment of hair part width, hair pull, and hair feathering test)
Dermoscopic examination of hair and scalp (trichoscopy)
Hair pluck (trichogram)
Microscopic hair analysis (light and polarization)
Scalp biopsy for histopathology and immunofluorescence studies
Wood lamp examination
Mycology, including KOH preparation and fungal cultures
Other microbiological services
Photographic methods (global photographic assessment, phototrichogram)
Blood test facilities (phlebotomy and laboratory services)
Access to non-dermatological clinical disciplines
Effective communication with nonmedical hair professions for referrals
The naked eye is right for the global look, but for close inspection, the additional use of a magnifying glass is practiced. The handheld, single-lens magnifier is the simplest and least expensive, most commonly used by dermatologists, usually at a magnification of 3× to 4×. Although the pathologist lives in a world magnified 100–1000 times, the clinician doesn’t benefit from a highly magnified view of the patient, lest he performs dermoscopy (10×) and is knowledgeable of the clinicopathologic correlations.
Dermoscopy is a noninvasive diagnostic tool that permits recognition of morphologic structures not visible to the naked eye. Dermatologists involved in the management of and scalp disorders have discovered dermoscopy to also be useful in their daily clinical practice. Scalp dermoscopy or trichoscopy is not only helpful for the diagnosis of hair and scalp disorders, but it can also give clues about the disease stage and progression.
Studies suggest that the use of dermoscopy in the clinical evaluation of hair and scalp disorders improves diagnostic capability beyond simple clinical inspection and reveals novel features of disease, which may extend our clinical and pathogenetic understanding. Therefore, dermoscopy of hair and scalp (trichoscopy) is gaining popularity in daily clinical practice as a valuable tool in differential diagnosis of hair and scalp disorders. This method allows viewing of the hair and scalp at high magnifications using a simple handheld dermatoscope (Heine Delta 20®, DermoGenius®, DermLite II PRO HR®, or DermLite DL3®), with alcohol as the interface solution. It can be combined with photography and digital imaging (Fig. 2.1).


Fig. 2.1
Trichoscopic examination with photography (DermLite Photo®)
Using dermoscopy, signature patterns are seen in a range of scalp and hair conditions. Some predominate in certain diseases; others can even help making a diagnosis in clinically uncertain cases.
Ultimately, examination of the scalp by dermoscopy can reassure patients with hair loss that they have received a thorough scalp examination, since patients with hair loss are very distressed and often feel that they are not properly examined.
The trichogram or hair pluck test is a semi-invasive technique for hair analysis on the basis of the hair growth cycle. It involves the forceful plucking of 50–100 hairs with a forceps from specific sites of the scalp and microscopic examination of the hair roots (Fig. 2.2a, b). A major objective of trichogram measurements is to evaluate and count the status of individual hair roots and to establish the ratio of anagen to telogen roots.


Fig. 2.2
(a) Plucking hair for trichogram. (b) Evaluating plucked hairs by light microscopy
Following the original description of the hair growth cycle by anatomist Mildred Trotter (1899–1991), studies on the dynamics of the follicular cycle have largely depended on the microscopic evaluation of plucked hairs with quantitative measuring of the number of individual hair roots. Subsequently, the trichogram technique was developed and standardized to serve as a diagnostic tool for evaluation of hair loss in daily clinical practice. For this purpose it is simple to perform, repeatable, and reasonably reliable under standardized conditions.
Since in 95 % of cases, hair loss is due to a disorder of hair cycling, trichogram measurements serve as a standard method for quantifying the hair in its different growth cycle phases as it relates to the pathologic dynamics underlying the loss of hair. The percentage of hair roots in anagen, catagen, or telogen reflects either synchronization phenomena of the hair cycle or alterations in the duration of the respective growth cycle phases. Finally, the presence of dystrophic hair roots signalizes a massive damage to anagen hair follicles, either by toxins or drugs in higher concentrations, or a severe alopecia areata.
The trichogram technique provides reliable results under the condition that hair samples are obtained under a standardized procedure.
In case of complaint of hair breakage or a pathologic hair feathering test or if there is a high percentage of broken-off hairs in the trichogram, light microscopic examination of the hair shaft is indicated. In general, the patient with a hair shaft disorder presents with an abnormality or change in hair texture, appearance, manageability (so called unruly hair), or ability to grow long hair. Paramount to the clinical evaluation is to determine whether there is increased fragility or not by performing a hair feathering test. An algorithmic approach to narrow the differential diagnosis is to classify hair shaft disorders into congenital or acquired conditions and in to those with (which consequently give rise to alopecia) and those without increased hair fragility. Finally, a systematic patient history and total clinical examination of the patient with emphasis on the teeth, nails, and sweat glands are needed, especially in the congenital disorders.
Usually, a hair mount and examination of shafts provides important clues to the diagnosis. Using the light microscope and polarization the great majority of congenital or acquired hair shaft disorders can be diagnosed in the office.
Many hair shaft abnormalities can also be recognized by dermoscopy.
Laboratory tests are useful when the probability of a disease being present is neither high nor low, since high degree of clinical certainty overrides the uncertainty of the laboratory data. Clinical suspicion is the determinant, and knowledge of clinical dermatology is the prerequisite for combining medical sense with economic sense in requesting laboratory tests.
The greater the number of different tests done, the greater the risk of getting false positive or irrelevant leads. The possibilities for laboratory errors increase in the automated multiple-screen procedures. Therefore, laboratory testing must be kept sharply focused.
Hair analysis refers to the chemical analysis of a hair sample. Its most widely accepted use is in the fields of forensic toxicology and, increasingly, environmental toxicology. Hair analysis is also used for the detection of recreational drugs, including cocaine, heroin, benzodiazepines, and amphetamines, and detection of the presence of illegal drugs. Chemical hair analysis may prove particularly useful for retrospective purposes when blood and urine are no longer expected to contain a particular contaminant, typically a year or less.
On the other hand, an increasing number of commercial laboratories are committed to providing multielemental hair analyses in which a single test is used to determine values for many minerals simultaneously. This type of analysis used by several alternative medicine fields with the claim that hair analyses can help diagnose a wide variety of health problems and can be used as the basis for prescribing natural chelation therapy, mineral, trace elements, and/or vitamin supplements. However, these uses remain controversial for a number of reasons:
Most commercial hair analysis laboratories have not validated their analytical techniques by checking them against standard reference materials.
Hair mineral content can be affected by exposure to various substances such as shampoos, bleaches, and hair dyes. No analytic technique enables reliable determination of the source of specific levels of elements in hair as bodily or environmental.
The level of certain minerals can be affected by the color, diameter and rate of growth of an individual’s hair, the season of the year, the geographic location, and the age and gender of the individual.Normal ranges of hair minerals have not been defined.
For most elements, no correlation has been established between hair level and other known indicators of nutrition status. It is possible for hair concentration of an element to be high even though deficiency exists in the body, and vice versa.
Microbiological studies are mandatory in inflammatory conditions of the scalp with scaling, crusting, and/or pustulation. While in children fungal infections (tinea capitis) predominate, in the adult, bacterial infection with Staphylococcus aureus is the most prominent. Diagnosis of fungal and bacterial skin infections requires swabs and test systems for direct visualization of pathogens (KOH preparation, Gram’s stain), cultures and special tests for species identification, and the availability of the appropriate laboratory infrastructure (Fig. 2.3).

Fig. 2.3
Reading mycological culture: positive dermatophyte culture identified as Microsporum canis
At times, repeated microbiological studies are recommended, since with prolonged antibiotic treatments, typically in folliculitis decalvans, new and resistant pathogens may emerge, e.g., Gram-negative folliculitis.
In some cases of alopecia, a diagnosis cannot be made based on results of physical examination, diagnostic hair techniques, and laboratory studies. This is particularly the case in the scarring alopecias. In these cases, a scalp biopsy may provide the specific diagnosis. In addition, it must be kept in mind that two types of alopecia may coexist within the same patient.
In all cases of scarring alopecia, a scalp biopsy is mandatory.
By definition, scarring alopecia is characterized by a visible loss of follicular ostia due to a destruction of the hair follicle on histopathological examination. The biopsy will help to identify the cause and rule out infiltrating malignant disease.
In the non-cicatricial alopecias where the follicular ostia are intact, a scalp biopsy is optional for morphometric studies on transverse sections (hair follicle density, anagen/telogen ratio, terminal/vellus hair ratio) or to detect specific findings for a particular diagnosis, such as trichomalacia in trichotillomania and the peribulbar lymphocytic infiltrate in alopecia areata.
In the inflammatory scarring alopecias with active inflammation, the type of inflammatory infiltrate (lymphocytic, neutrophilic, mixed, granulomatous), the pattern of inflammation, and its relation to the hair follicle usually enable a specific diagnosis. Where active inflammation is missing, an elastin stain will help to identify the scarring process and its pattern.
In a study of 136 scalp biopsies obtained for histopathology and direct immunofluorescence (DIF) studies at the Department of Dermatology, University Hospital of Zurich, a definitive diagnosis was made in 126 of 136 biopsies. In 97 % the definitive diagnosis was made on the basis of histopathology alone. Characteristic DIF patterns for lichen planopilaris and cutaneous lupus erythematosus showed high specificity (98 %) but low sensitivity (34 %) for lichen planopilaris and high specificity (96 %) and sensitivity (76 %) for lupus erythematosus.
The diagnostic yield of DIF studies performed on scalp biopsies is highest when the diagnosis of cutaneous lupus erythematosus is in question.
Frequent problems related to the scalp biopsy are the reluctance of many dermatologists to perform a scalp biopsy and therefore lack of experience with the proper procedure and the lack of familiarity of many pathologists with scalp histopathology. Scalp biopsies are often inadequately performed: superficial (without subcutaneous tissue), small, often tangential to the hair follicle, and with crush artifacts. Finally, the hair follicle and its derangements are complex and dynamic, while a biopsy only gives a momentary snapshot of the pathology.
Nevertheless, if done and examined properly, the scalp biopsy should be an easy, relatively painless, and bloodless procedure that represents an invaluable adjunct for confirming or establishing the diagnosis of a specific type of alopecia, whether scarring or non-scarring.
For an in-depth discussion of the diagnostic techniques, the reader is encouraged to refer to the respective textbooks.
2.3 Quantifying Hair Loss
Reliably assessing the actual shedding of hair is a crucial diagnostic point in trichological practice. To fulfil office requirements, the test should be easy, noninvasive, and not time-consuming. Many methods have been proposed, but all need standardization.
The hair pull represents a poorly sensitive method, while telogen percentage in the trichogram does not correlate with severity of hair loss.
Daily hair counts are done by the patient at home to provide a quasi quantitative assessment of the number of hairs shed daily. For this purpose, the patient is instructed to collect all hairs that fall out during the morning grooming, including hairs on the pillow, sink, comb, brush, and shoulders as well as all hairs that come out with the morning shampoo. Placing a piece of nylon netting or gauze over the drain will help secure hairs otherwise lost during washing. The entire morning’s collection is placed in a clear, smooth, plastic bag. The date and information on whether the hair has been shampooed or not is written on a label placed on the bag. The patient is also asked to count every hair in the bag and to record the total count on the label as well. Typically, hair collection is done for fourteen consecutive days, and all fourteen bags are brought to the physician’s office. It is more practical, to ask patients to collect and count the hairs on the five to seven days prior to the trichogram (daily hair counts) and after washing the hair following the trichogram (hair wash test).
The amount of normal hair shed may vary from 35 to 180 hairs, depending on the amount of scalp hair and seasonal factors. The number is usually higher on the day of shampoo, especially when the hair is not shampooed daily. In diffuse telogen effluvium and anagen effluvium, the number of hairs shed daily is in the 100s, while in androgenetic alopecia, it may well be less than 100.
Therefore, it is not wise to trust in rules of thumb, such as a daily hair count of up to 100 is normal, when evaluating hair loss.
While the daily hair count is a cumbersome procedure, it has been proposed that the wash test is probably the best method to adopt. In the wash test, the patient, five days after the last shampoo, washes the hair in the sink with its drain covered by gauze. The hairs entrapped in the gauze are then counted. In one study assessing hair shedding in children, the wash test proved to be reliable, with a cutoff point of normality close to 11. Wash test values increase with age. Age-dependent normal values in adults do not exist.
In an attempt to find a simple method to evaluate reliably the diagnosis and activity of androgenetic alopecia and telogen effluvium, Guarrera et al. adopted the modified wash test, which accomplishes such a task through the assessment of the number of shed hair and the vellus percentage. The collected hairs after washing are counted and divided into ≤3 cm and ≥5 cm in length. The technique has originally been adapted to differentiate telogen effluvium from female androgenetic alopecia. The test demonstrated that in female androgenetic alopecia, 58.9 % of hair is vellus, whereas in chronic telogen effluvium only 3.5 %.
Eventually, measurement of the effects of treatment needs to be quantified reliably. The method should be more sensitive than the wash test and capable of analyzing relevant parameters of hair growth, which are hair density, hair diameter, hair growth rate, and anagen/telogen ratio. For this purpose, computer-assisted image analysis has been proposed: Some patents have been filed and publications followed since the 1980s. However, it soon became clear that hair is a tricky material for automated computer-assisted image analysis and that numbers might not all be considered as reflecting hair measurements. Physical properties of hair, that is, the object and the variability of the skin, and their background are very complex. The multilayered fiber is composed of a nonpigmented cuticle, a cortex with presence or absence of pigment granules, and a medulla filled with proteinaceous material or air cavities. On top, its organization and orientation at the exit point from the skin must also be taken into account. A follicular unit comprising a number of hair follicles (occasionally up to 5) may exit from a single orifice at the skin surface, and it may be difficult to count individual hair fibers. Some attempts have suggested that use of fully automatic systems may be an option, but this has not been made available to the public.
A software named TrichoScan® combining epiluminescence microscopy with digital image analysis has been proposed and marketed for automated image analysis of scalp hair. This method requires the use of hair dyes for improved detection of less pigmented and thinner hair. Advocates for the method declare that a system must be able to analyze the biological parameters that constitute hair growth, which are (1) hair density (n/cm2), (2) hair diameter (μm), (3) hair growth rate (mm/day), and (4) anagen/telogen ratio. Intra-class correlation of approximately 91 % within the same operator and an interclass correlation of approximately 97 % for different operators suggested that the method was very precise and reproducible.
Using standardized photographic equipment and calibrated processing for contrast-enhanced phototrichogram (CEPTG) analysis, van Neste established a protocol that was equally sensitive as scalp biopsies for hair detection and growth staging. Taking this as a reference method, a study was performed to evaluate the advantages and limits of TrichoScan® for human hair growth analysis. The study was prompted by a number of variations that were unexpected after considering the original claims for accuracy promoting the TrichoScan® method for hair growth measurement. The investigation did not corroborate these claims. With the available software, numbers were displayed for hair counts (all fibers detected by the software in the target area and those that touched the border of the target area). This number is also split into resting hair (telogen) and those considered growing, that is, in anagen phase of the hair growth cycle. The commercially available software provided to dermatologists and hair clinics originally did not display the thickness of hair fibers and the hair growth rate. Although cumulative thickness may be an indirect way to approach the hair thickness measurement, it provides a global measure that depends on hair cycle duration. Also, it was challenged that TrichoScan® measures growth accurately. First, there are no growth rates on the data display. Second, the precision of anagen hair detection is not optimal. Indeed, the anagen percentage was underestimated (difference >5 %) in two out of four scalp sites as well as in the beard area, but it was overestimated when thinning was more important (overestimation of 32 % anagen hair proportion in the vertex). A number of these errors (especially with thin hair detection) have been described by others using the TrichoScan® method in normal scalp sites, especially a density that was underestimated by 22 % and the lack of detection of thinner hair. As thinning is a phenomenon associated with androgenetic alopecia, published documents and our experimental study clearly documented that especially thin hair counts as well as growth staging generated by the TrichoScan® method may not be considered as reliable. Therefore, it was concluded that TrichoScan® in the present form would not qualify as a test method for quantification of hair loss according to the internal and other standards particularly in patients with androgenetic alopecia.
Stay updated, free articles. Join our Telegram channel
Full access? Get Clinical Tree





